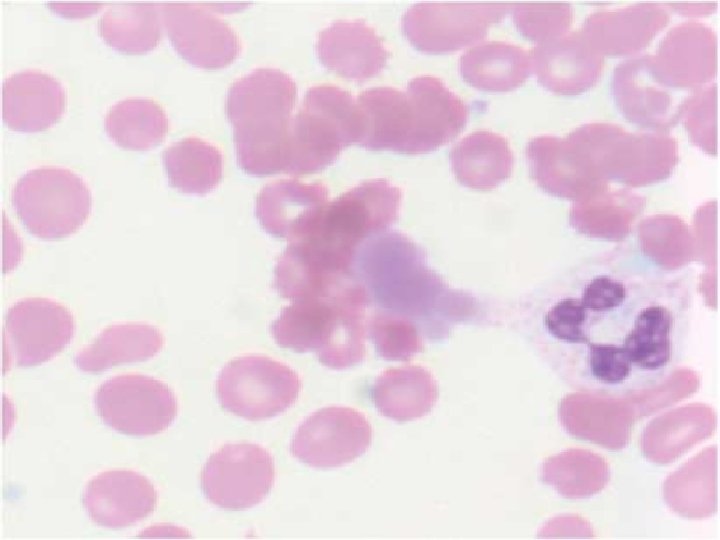

Wintrobe MM Buell MV Hyperproteinemia associated with multiple



ΙΣΤΟΡΙΚΗ ΑΝΑΔΡΟΜΗ • Wintrobe MM, Buell MV. Hyperproteinemia associated with multiple myeloma. Bull Johns Hopkins Hosp 1933; 52: 156 -65. • Lerner AB, Watson CJ. Studies of cryoglobulins I: unusual purpura associated with the presence of a high concentration of cryoglobulin (cold precipitable serum globulin). Am J Med Sci 1947; 214: 410 -15. • Meltzer M, Franklin EC. Cryoglobulinaemia: a study of 29 patients. I: Ig. G and Ig. M cryoglobulins and factors effecting cryoprecipitability. Am J Med 1966; 40: 828 -36

Charles ED. KI June 2009


















Type 1 MPGN • • • Endocapillary mesangial-cell proliferation Glomerular infiltration by activated macrophages Glomerular basement membrane shows double contours Subendothelial deposits of Ig. M, Ig. G, and complement components are observed by immunofluorescence and electron microscopy Vasculitis of small renal arteries is present in 30% of cases Eosinophilic PAS-positive intraluminal deposits




Saadoun. Rheumatology 2007; 46: 1234– 1242



KDIGO Recommendations • For e. GFR >50 m. L/min/1. 73 m 2, pegylated interferon and ribavirin • For e. GFR 15 to <50 m. L/min per 1. 73 m 2, monotherapy with pegylated interferon • For e. GFR <15 m. L/min per 1. 73 m 2 (including patients on hemodialysis); monotherapy with standard interferon that is dose adjusted for a glomerular filtration rate less than 15 m. L/min per 1. 73 m • Antiviral treatment is recommended for at least 12 months

Additional KDIGO Recommendations • Among MPGN patients with nephrotic-range proteinuria and/or rapid loss of kidney function and an acute flare of cryoglobulinemia, one of the following therapies should be considered: Plasma exchange (3 liters of plasma thrice weekly for two to three weeks) Rituximab (375 mg/m 2 per week for four weeks); OR Cyclophosphamide (2 mg/kg per day for two to four months) Plus Methylprednisolone pulses (0. 5 to 1 g/day for three days). • Treated with ACEI or ARB to reduce proteinuria and achieve target blood pressure goals • Relapses of systemic cryoglobulinemia and membranoproliferative glomerulonephropathy may be treated with additional doses of rituximab

- Slides: 47